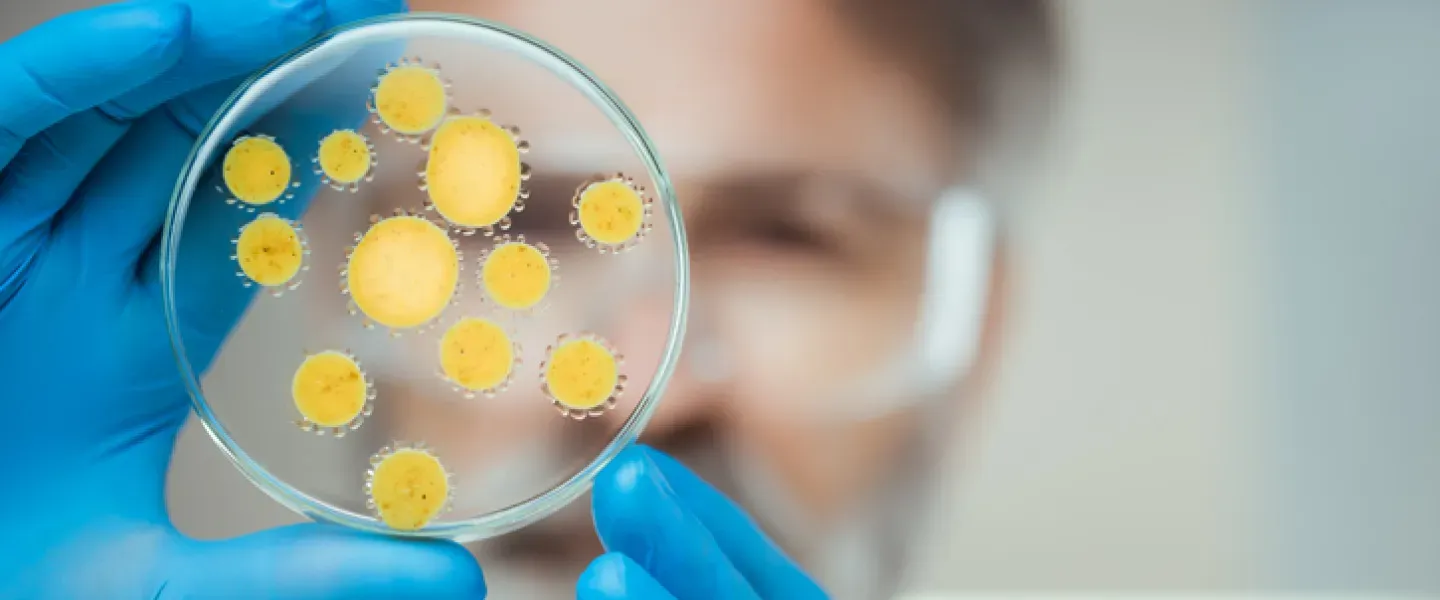
Doctor working in laboratory with a petri dish

Because new and potentially lethal infections continually evolve, infectious diseases, a subspecialty of EVMS Department of Medicine, is a diverse and ever-changing field.
According to the National Institutes of Health, infectious diseases kill more people worldwide than any other single cause. Fortunately, this isn't the case in the United States, largely because of the quality and availability of our medical care.
How are we exposed to germs?
Germs exist everywhere in the environment and cause infections through contact, such as touching, eating, drinking, or even breathing. Insect and animal bites, as well as social contact, like kissing and sexual contact, can also spread germs.